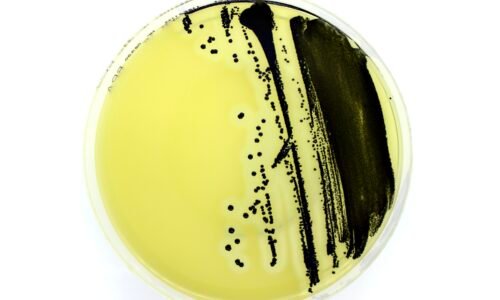

- Distributor Liofilchem, Liofilchem, Liofilchem Distributor, Liofilchem Jakarta, news
- 4 tahun ago
Baird Parker Agar (REF: 10020 – 10224 – 163512)
Baird Parker Agar (REF: 10020 – 10224 – 163512) Media Selektif untuk [...]
- Labs
- 05882

Services for the Pharmaceutical Industry – Antimicrobial Resistance Management Lio ..

Baird Parker Agar (REF: 10020 – 10224 – 163512) Media Selektif untuk Iso ..
Baird Parker Agar (REF: 10020 – 10224 – 163512) Media Selektif untuk Iso ..

Services for the Pharmaceutical Industry – Antimicrobial Resistance Management Lio ..

Baird Parker Agar (REF: 10020 – 10224 – 163512) Media Selektif untuk [...]